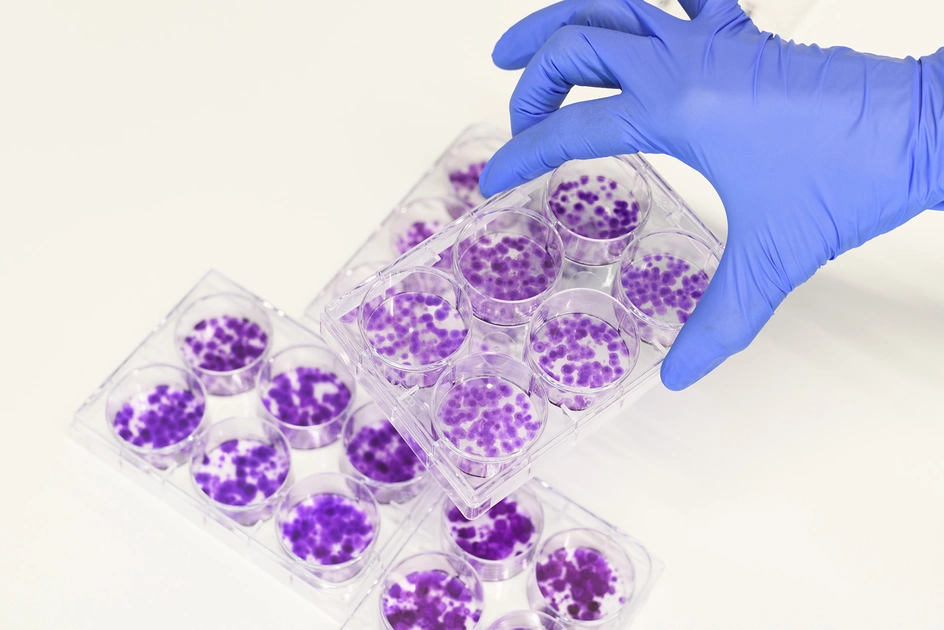

La recherche au CHUV

La recherche fait partie des trois missions de base d’un hôpital universitaire. En collaboration prioritaire avec l’Université de Lausanne et sa Faculté de biologie et de médecine, le CHUV s’investit dans des activités de recherche clinique, translationnelle et fondamentale. Des partenariats sont également développés avec l’EPFL, les hautes écoles et les institutions de recherche suisses et internationales.